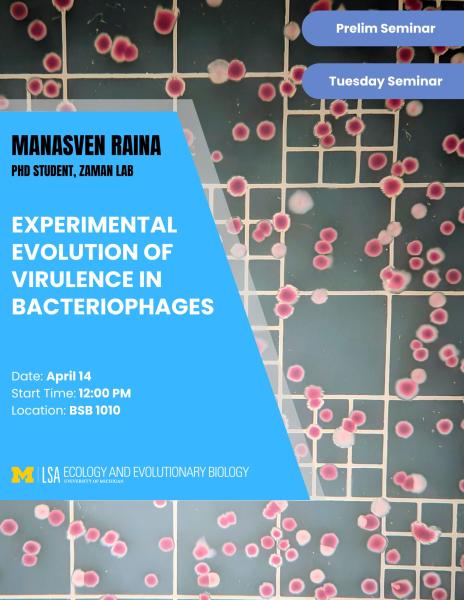

EEB Tuesday Seminar Series - Experimental evolution of virulence in bacteriophages
Manasven Raina, PhD student, Zaman Lab
Description: Virulence is the measure of harm inflicted on a host by a parasite. It is a central component of parasite fitness and forms one part of a widely studied trade-off in evolutionary biology; the virulence-transmission tradeoff. The evolution of virulence has been studied extensively over the last 4 decades but any changes in virulence are largely investigated either in theory or simple empirical experiments that focus on one-to-one host-parasite relationships. In chapter 1 of my dissertation work, I will use phage-bacteria model systems to empirically investigate how parasite virulence evolves in assemblages with multiple hosts and parasites. In addition to being tractable models for host-parasite coevolution, bacteria-phage communities can be used as a kind of living epidemiological model. In chapter 2, I will use phage pathogens with starkly different life cycles (chronic and temperate) to conduct experimental tests of evolutionary-epidemiological theory and question if pathogen virulence in “twindemic” scenarios adapts to the predicted epidemiological optima. Finally, when multiple infections are common, pathogens exhibit unique life-cycle strategies that may prioritize virulence or prudence. Recent discoveries of phage signaling systems raise questions about how switching between virulent and prudent life cycles occurs molecularly, and the role phage-to-phage communication plays. In the final chapter, I will investigate phage communication’s role in modulating virulence.
| Building: | Biological Sciences Building |
|---|---|
| Event Type: | Workshop / Seminar |
| Tags: | Bsbsigns, department of ecology and evolutionary biology, developmental biology, Ecology & Biology, Ecology And Evolutionary Biology, eeb, Environment, environmental, evolution, evolutionary biology |
| Source: | Happening @ Michigan from Ecology and Evolutionary Biology, EEB Tuesday Lunch Seminars |